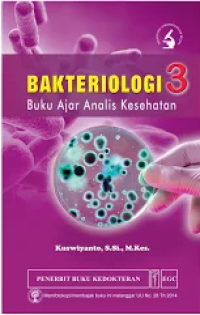
Image of Bakteriologi 3: Buku Ajar Analis Kesehatan

Text
Bakteriologi 3: Buku Ajar Analis Kesehatan
Penilaian
0,0
dari 5Tidak Tersedia Deskripsi
Judul Seri
-
No. Panggil
616.01 KUS b
Penerbit
Jakarta : EGC, 2022
Deskripsi Fisik
xii, 134 hal; 15,5 x 24 cm
Bahasa
Indonesia
ISBN/ISSN
978-979-044-791-2
Klasifikasi
616.01
Edisi
-
Subjek
-
Info Detail Spesifik
-
Pernyataan Tanggung Jawab
Kuswiyanto
Lokasi Koleksi
Barcode ID
Status
Reservasi
#
Perpustakaan Kampus A
616.01 KUS b
B04799
Tersedia - Indonesia
#
Perpustakaan Kampus A
616.01 KUS b
B04800
Tersedia - Indonesia
Tidak ada file PDF yang tersedia
Versi lain/terkait
Tidak tersedia versi lain
Komentar
Anda harus masuk sebelum memberikan komentar
 Computer Science, Information & General Works
Computer Science, Information & General Works  Philosophy & Psychology
Philosophy & Psychology  Religion
Religion  Social Sciences
Social Sciences  Language
Language  Pure Science
Pure Science  Applied Sciences
Applied Sciences  Art & Recreation
Art & Recreation  Literature
Literature  History & Geography
History & Geography